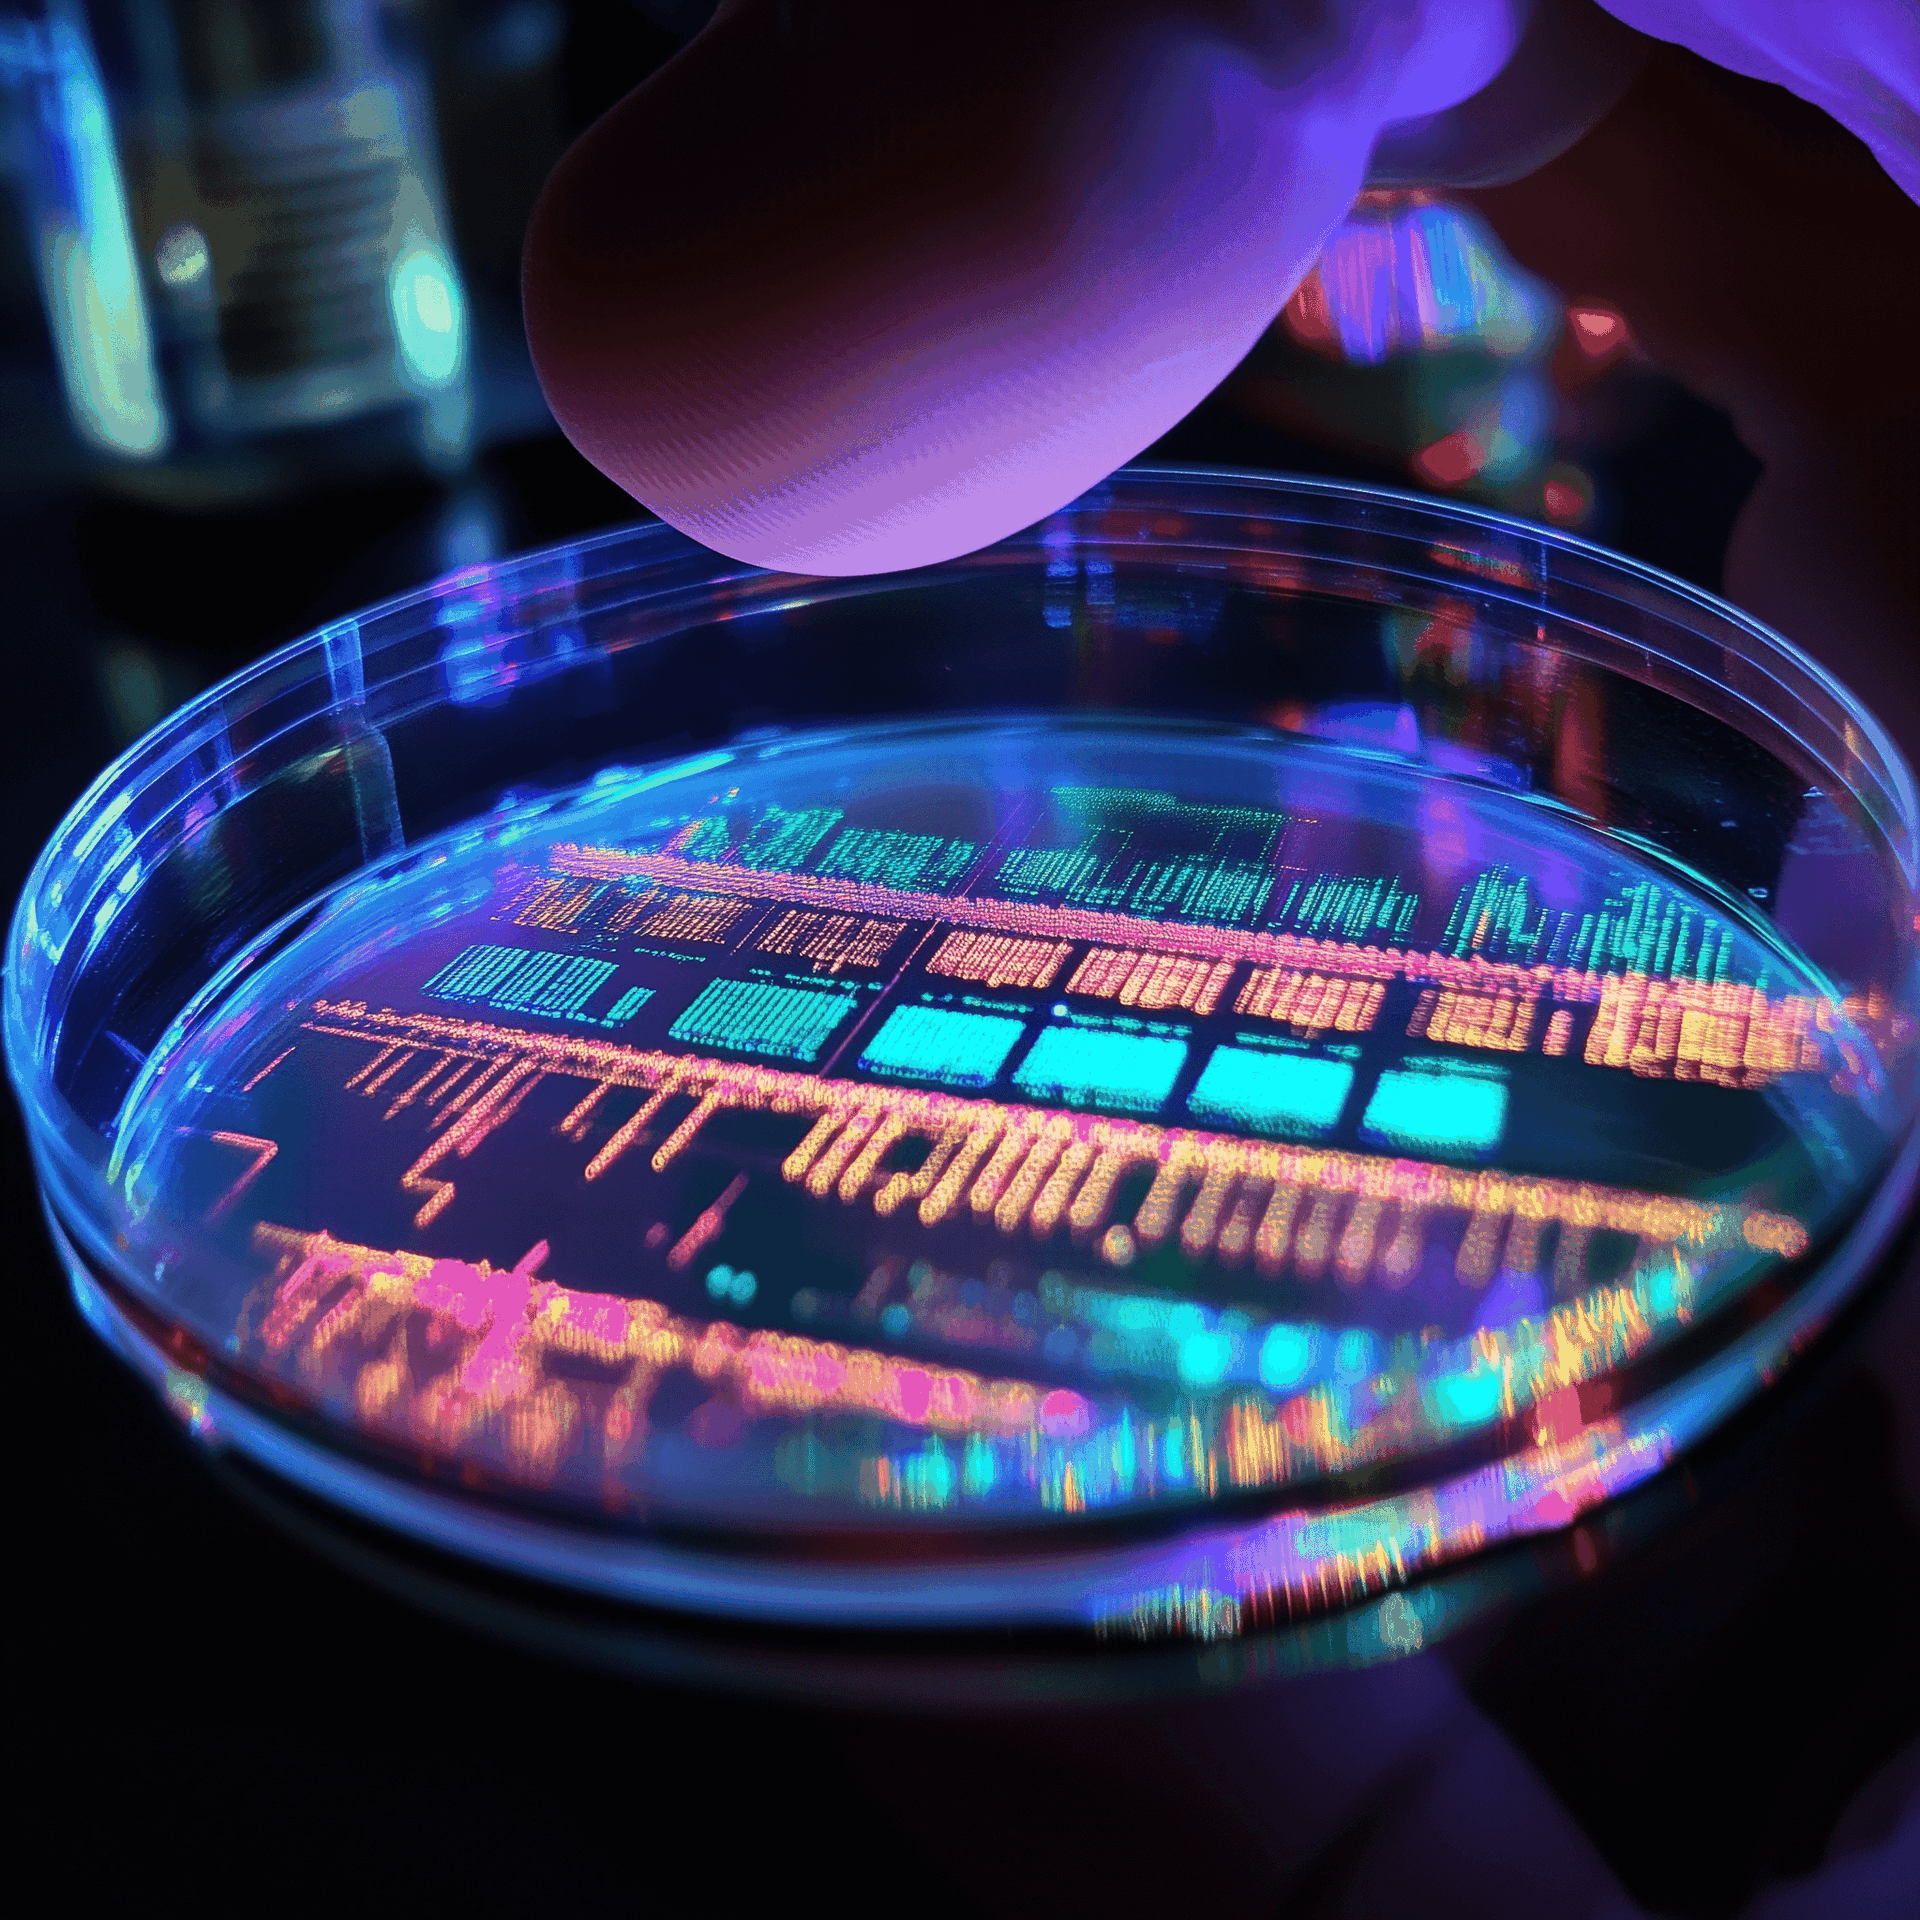

Wij helpen je graag verder
Stel je vraag aan het ChipNL Competence Centre
Heb je een idee, initiatief of vraag over talent, technologie of samenwerking in de halfgeleidersector? Vul het formulier in en wij zorgen dat je vraag direct bij de juiste contactpersoon terechtkomt.
Stuur je liever een mail? Dat kan ook: communicatie@cccnl.nl
Brainport Development namens ChipNL Competence Centre
Achtseweg Zuid 159-H
5651 GW Eindhoven
040 751 2424
Neem contact op met ons team
Let’s talk
Geef aan waar je vraag over gaat, zodat we je direct met de juiste persoon kunnen verbinden.
As the national semiconductor hub, we empower organizations to excel and help the sector thrive